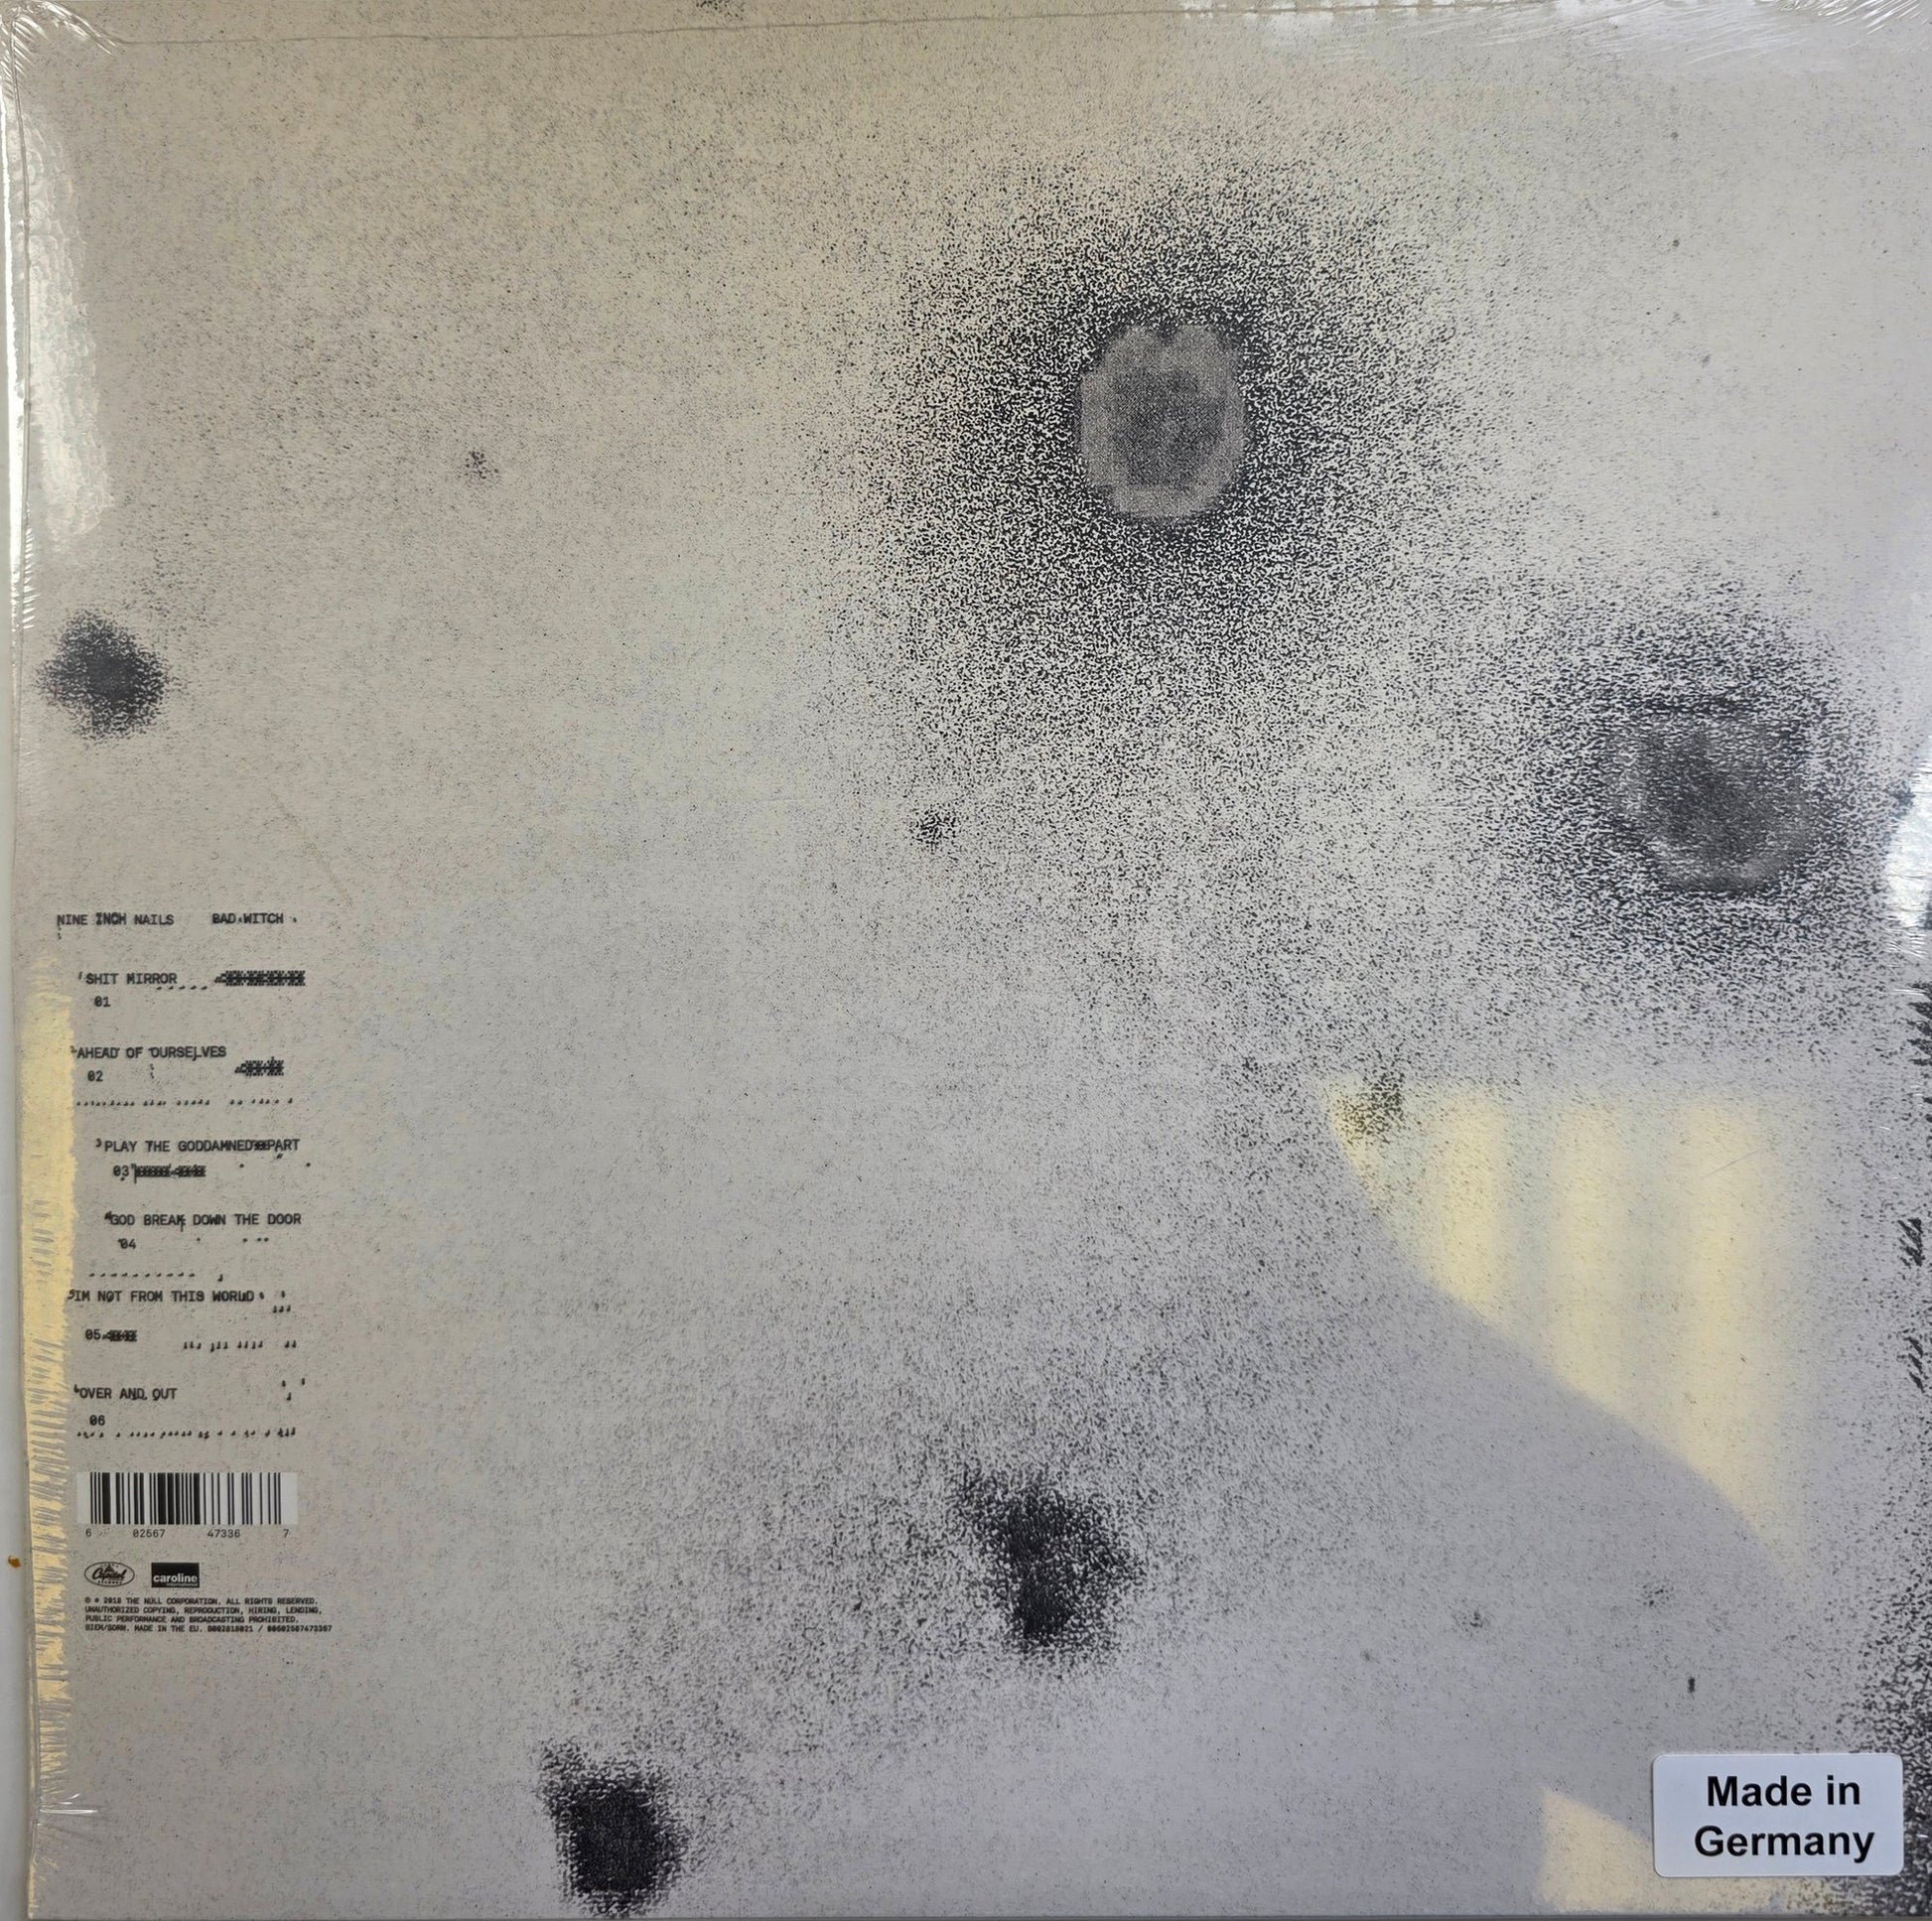

The More You Buy The More You Save
Free Postage Over £40
The More You Buy The More You Save
Free Postage Over £40
The More You Buy The More You Save
Free Postage Over £40